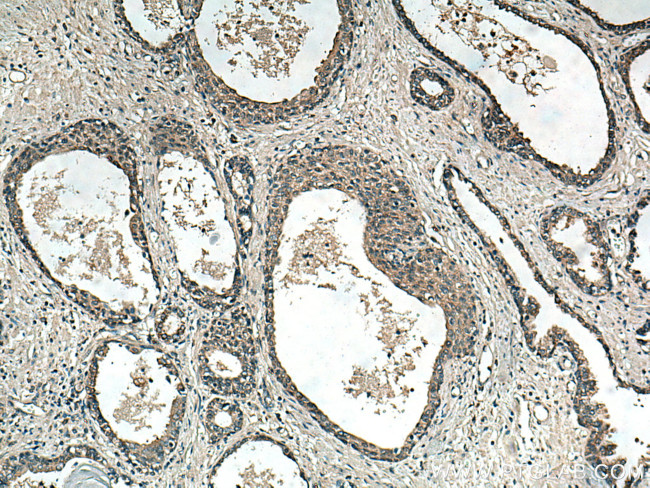
RNF113A Antibody in Immunohistochemistry (Paraffin) (IHC (P))

Search
Proteintech
RNF113A Polyclonal Antibody
{{$productOrderCtrl.translations['antibody.pdp.commerceCard.promotion.promotions']}}
{{$productOrderCtrl.translations['antibody.pdp.commerceCard.promotion.viewpromo']}}
{{$productOrderCtrl.translations['antibody.pdp.commerceCard.promotion.promocode']}}: {{promo.promoCode}} {{promo.promoTitle}} {{promo.promoDescription}}. {{$productOrderCtrl.translations['antibody.pdp.commerceCard.promotion.learnmore']}}
产品信息
27018-1-AP
种属反应
宿主/亚型
分类
类型
抗原
偶联物
形式
浓度
规格
纯化类型
保存液
内含物
保存条件
运输条件
产品详细信息
Aliquoting is unnecessary for -20°C storage.
靶标信息
This intronless gene encodes a protein which contains a C3H1-type zinc finger domain and a C3HC4 Ring-type (Really Interesting New Gene-type) zinc finger domain. The Ring-type zinc finger domain is identified in various tumor suppressors, DNA repair genes and cytokine receptor-associated molecules, and is probably involved in mediating protein-protein interactions. [provided by RefSeq, May 2010].
仅用于科研。不用于诊断过程。未经明确授权不得转售。
生物信息学
蛋白别名: Cwc24 homolog; E3 ubiquitin-protein ligase RNF113A; RING finger protein 113A; unnamed protein product; Zinc finger protein 183; zinc finger protein 183 (RING finger, C3HC4 type); ZNF183
基因别名: Cwc24; RNF113; RNF113A; TTD5; ZNF183
UniProt ID: (Human) O15541
Entrez Gene ID: (Human) 7737